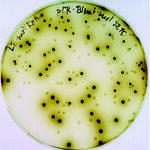
Biokatalytische Herstellung wertvoller Zwischen­produkte

Beispielhafte Projekte aus der Fördertätigkeit der DBU
-
BiocatCollection macht Enzymvielfalt verfügbar
In Hochschulen, Instituten und Forschungseinrichtungen lagert ein Enzymschatz, den es für die Entwicklung nachhaltiger Produkte und Prozesse zu nutzen gilt.
Weiterlesen -

Elektromotoren umweltschonend imprägnieren
Ein neues Imprägnierverfahren für fest stehende Bauteile großer Elektromotoren – die Statoren – verkürzt die Bearbeitungszeit und entlastet die Umwelt.
Weiterlesen -
Biotechnologische Produktion von Perillasäure
Erstmals wurde ein umweltgerechter Bioprozess entwickelt, der die technische Synthese natürlicher Monoterpensäuren ermöglicht.
Weiterlesen -

Nachhaltige Baustoffe aus nachwachsenden Rohstoffen
Sandwichwerkstoffe zeichnen sich durch hohe Stabilität bei vergleichsweise geringem Gewicht aus. Ziel dieses Projektes war es, ein leichtes Naturstoff-Sandwichmaterial (LNS) auf Basis nachwachsender Rohstoffe herzustellen sowie Produktprototypen aus LNS-Werkstoffen zu entwickeln.
Weiterlesen -

Ein Ökohaus macht Schule
Die Ökologie-AG Wöhlerschule bekam mit dem Abriss der alten Baracke auf dem Schulhof eine einmalige Chance: Sie konnte an ihrer Stelle ein Ökohaus errichten, das als Informationszentrum für den Unterricht, für Arbeitsgemeinschaften und die gesamte Schulgemeinde dienen sollte.
Weiterlesen -

Umweltfreundliche Ausbildung hat Vorfahrt
Was können kleine und mittelständische Güterkraftverkehrsunternehmen für den Umweltschutz tun? Und welche Ressourcen stehen dafür zur Verfügung?
Weiterlesen -

Biokatalytische Herstellung wertvoller Zwischenprodukte
In diesem Forschungsprojekt wird ein wesentlicher Beitrag zur Entwicklung von Basistechnologien für hochselektive Biooxidationen und Hydrierungen mit isolierten Oxidoreduktase-Enzymen erarbeitet.
Weiterlesen -

Schulpartnerschaften.de - Innerdeutsche Begegnungen zu Umweltthemen
Die Jugend zusammenbringen und die Gemeinsamkeit zwischen den Deutschen aus Ost und West stärken - das ist das Ziel der Initiative Schulpartnerschaften.de, die 2001 vom damaligen Bundespräsidenten Rau ins Leben gerufen wurde.
Weiterlesen -

Die eigene Umwelt wieder lieben lernen
Während der Zeit des »Eisernen Vorhangs« war der Zutritt in das Naturschutzgebiet "Untere Morava" in der Slowakei streng untersagt – die Region lag im Sperrgebiet. Das soll sich ändern: Schüler und Bürger werden dazu ermuntert, an der Gestaltung der Natur- und Siedlungsräume ihrer Umgebung mitzuwirken.
Weiterlesen -

Flutverfahren reduziert Lackabfall
Wenn Holz im Außenbereich verwendet wird, muss es dauerhaft wetterbeständig sein und gegen Schädlinge geschützt werden.
Weiterlesen